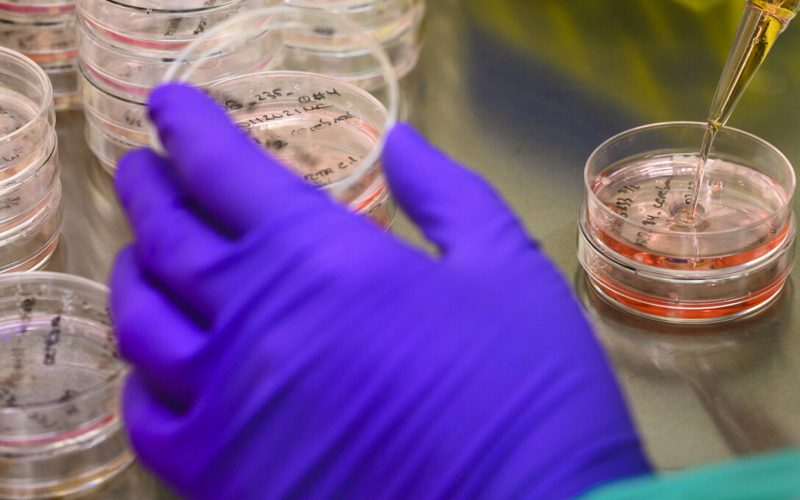
A gloved hand holds a petri dish.

Research at UMC Utrecht has identified 29 novel antibodies against the bacterium Klebsiella pneumoniae, an important cause of drug-resistant infections. Using genetic and functional approaches, the researchers also managed to unravel how these antibodies interact with antigens on the bacterial surface. Finally, they found that some of these novel antibodies act synergistically to neutralize this pathogen.
The increasing problem of antimicrobial resistance (AMR) urgently calls for the development of alternative therapies against bacterial infections. A promising strategy is to boost the immune system through antibodies, either indirectly via vaccination or directly via therapeutic antibodies. One of the major mechanisms through which antibodies can kill bacteria is through leveraging activation of the complement system upon binding to bacterial surface antigens. Activation of the complement cascade can lead to bacterial killing via insertion of large pores into the cell membrane as well as via phagocytosis. However, how exactly antibody-mediated bacterial killing via complement takes place remains poorly understood. In addition, there is a need for new tools to identify antibacterial antibodies and to investigate in depth how these antibodies interact with bacterial surface structures. Prof. Suzan Rooijakkers and colleagues from the Department of Medical Microbiology at UMC Utrecht established an innovative approach to identify novel anti-bacterial antibodies from human memory B cells.
Prof. Suzanne Rooijakkers
Novel antibodies identified
Although it is common to stain B cells with purified antigens, the investigators decided to go for a more holistic approach and stain the B cells with whole living bacteria, thereby keeping the antigens in their natural context. Using this approach, they successfully identified 29 unique antibodies against the opportunistic human pathogen Klebsiella pneumoniae, an important cause of hospital-acquired infections with increasing antimicrobial resistance. The researchers revealed that specific antigens on the bacterial surface determined the antibody’s capacity to drive complement activation and bacterial killing. Furthermore, analyses of antibody mixtures revealed that some antibodies acted synergistically by enhancing each other’s binding to the bacterial surface.
Principal investigator Suzan Rooijakkers, Professor of Microbiology at UMC Utrecht, concluded: “We anticipate that our new approach will accelerate discovery of monoclonal antibodies against bacterial pathogens. Also, our work will stimulate the field to explore if antibody combinations are a promising route to develop potent antibody-based therapies against problematic infections.”
Lans SPA van der, Bardoel BW, Ruyken M, Haas CJC de, Baijens S, Muts RM, Scheepmaker LM, Aerts PC, Wout MFL van ‘t, Preiner J, Marijnissen RJ, Schuurman J, Beurskens FJ, Kerkman PF, Rooijakkers SHM. Agnostic B cell selection approach identifies antibodies against K. pneumoniae that synergistically drive complement activation. Nature Communications 2024;15:8100
Blog by prof. Suzan Rooijakkers on this publication: “Antibodies need teamwork!” Published on Springer Nature Research Communities, September 20, 2024